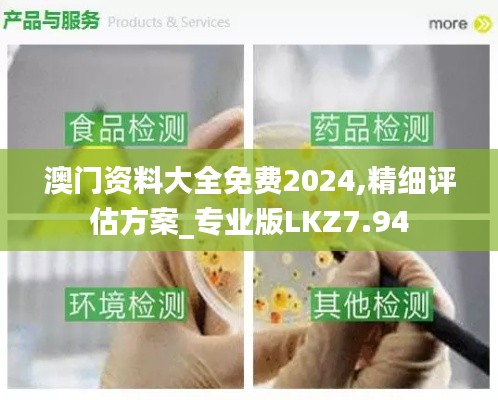

澳门概况
澳门是一个拥有丰富历史文化背景和独特地理位置的特别行政区,位于中国南部的珠江口西岸,与香港隔海相望。澳门作为东南亚重要的商业和旅游中心,吸引着数百万游客前来游玩和投资。近年来,澳门的经济发展迅速,博彩业成为其经济支柱,同时,其旅游业和相关服务业也持续增长,形成了多元化的经济结构。
澳门的旅游资源
澳门以其丰富的旅游资源而闻名,著名的地标包括大三巴牌坊、妈阁庙、威尼斯人度假村等。这些景点不仅展示了澳门的历史与文化,还体现了中西合璧的独特风格。随着2024年的临近,澳门也在不断完善其旅游基础设施,以便为游客提供更为舒适和便利的旅行体验。
博彩业的崛起
澳门被誉为“世界博彩之都”,博彩公司遍布整个地区,吸引了大量游客前来体验博彩的乐趣。澳门的博彩业自21世纪初开始快速发展,逐渐超越了拉斯维加斯,成为全球最大的博彩市场。面对2024年即将到来的各种挑战和机遇,澳门的博彩业也在不断进行内部改革与创新,努力保持其市场竞争力。
文化活动的多样性
澳门是一个文化交融的地方,这里不仅有丰富的传统文化活动,还有许多现代艺术展览和音乐节等。每年,澳门都会举办各种文化活动,如澳门国际音乐节、澳门艺术节等,这些活动不仅吸引了游客,也丰富了当地居民的文化生活。2024年,澳门有望推出更多特色活动,以促进文化交流和社区参与。
澳门的美食文化
作为一个历史悠久的城市,澳门的美食文化同样值得一提。澳门的饮食受到了葡萄牙、广东等多种文化的影响,形成了独特的“澳门风味”。葡式蛋挞、猪扒包、马交洲海鲜等美食深受游客欢迎。到2024年,澳门预计会推出更多的新餐饮项目和美食节,进一步提升其在国际美食界的知名度。
教育与人才发展策略
澳门在教育方面一直以来重视人才的培养与发展,吸引了众多国际学生前来留学。澳门的高等教育机构不断提升办学水平,致力于培养适应社会需求的高素质人才。面对2024年澳门经济发展的新需求,当地政府还将进一步加大对教育和培训的投入,提升人才培养质量,为社会的可持续发展提供强有力的支持。
绿色发展与可持续性
面对全球气候变化的严峻形势,澳门也在积极探索绿色发展之路。2024年,澳门计划推出一系列可持续发展措施,包括加强对公共交通的投资、推广清洁能源使用、鼓励绿色建筑等。澳门希望通过这些措施,不仅改善当地居民的生活环境,同时也吸引更多追求可持续旅游的游客。
科技与创新的融合
进入数字化时代,澳门的各行各业都在寻找科技赋能的机会。智能旅游、在线博彩、虚拟现实体验等新兴行业正在逐步兴起。地方政府鼓励企业通过技术创新提升服务质量和效率,预计到2024年,澳门会涌现出更多创新型企业和项目,为经济发展注入新活力。
国际化的合作与交流
澳门作为中国对外开放的重要窗口,与多个国家和地区建立了良好的合作关系。地方政府鼓励各类国际交流活动,为当地居民提供了解世界各地文化的机会。除了吸引国际游客,澳门还希望通过文化、教育、经贸等多个领域的合作,进一步提升自身的国际影响力,为未来的发展打下坚实的基础。
展望2024
随着2024年的到来,澳门面临着新的发展机遇和挑战。在未来的发展过程中,澳门将继续致力于提升自身的综合竞争力,以适应快速变化的经济环境。无论是产业结构的优化,还是文化旅游的提升,澳门都有着明确的发展目标和战略。相信在不久的将来,澳门会以更加开放、多元和包容的姿态,向世界展示其独特的魅力。
结论
澳门作为一个充满活力的城市,正在不断地为游客提供创新的旅游体验。无论是在文化、教育、经济还是可持续发展方面,澳门都在向着更加美好的未来迈进。随着2024年的到来,这个充满机遇的城市必将吸引更多的人们前来探索和体验,展现出独特的澳门风采。
转载请注明来自福建光数数字技术有限公司,本文标题:《澳门资料大全免费2024,精细评估方案_专业版LKZ7.94》

蜀ICP备2022005971号-1
还没有评论,来说两句吧...